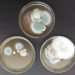

Koronavirusu Lietuvoje užsikrečiant vis daugiau žmonių, „Eurovaistinės“ farmacininkai sako sulaukiantys vis dažnesnio klausimo, ką daryti jeigu koronavirusas buvo nustatytas artimajam?
Jeigu COVID-19 diagnozuotas jūsų šeimos nariui, farmacijos specialistė Elvyra Ramaškienė sako, kad labai svarbu vengti bet kokio kontakto su juo. „Jeigu jūsų artimasis susirgo lengva ligos forma, tokiu atveju, jam gali būti leista gydytis namuose, tačiau svarbu izoliuotis nuo kitų šeimos narių. Geriausia, jeigu jis galėtų gyventi atskirai arba bent būtų kitame kambaryje“, – sako „Eurovaistinės“ atstovė.
Atskiras puodelis, šakutė ir net rankšluostis
Svarbu atkreipti dėmesį, kad šiuo virusu užsikrėtę žmonės turėtų ne tik leisti laiką kitoje patalpoje, bet jeigu yra galimybė, naudotųsi ir atskiru vonios kambariu. Pasak E. Ramaškienės, jeigu tokios galimybės nėra, svarbu užtikrinti, kad užsikrėtęs žmogus nesusitiktų su kitais šeimos nariais ir patalpos būtų kruopščiai dezinfekuojamos.
Jai antrina ir vaistininkė Laura Gogogienė. Ji sako, kad tuo atveju, jeigu sergantys lieka kartu namuose, svarbu, jog jis dėvėtų medicininę kaukę ir vienkartines pirštines bei nepamirštų reguliariai keisti apsaugos priemonių.
Farmacijos specialistė taip pat akcentuoja, kad koronavirusu sergantis žmogus turėtų naudoti atskirus namų apyvokos daiktus – rankšluosčius, indus, taip išvengiant papildomo kontakto su kitais šeimos nariais.
Ne mažiau svarbu ir tai, kad sergantysis reguliariai plautų rankas, laikytųsi čiaudėjimo ir kosėjimo higienos – tai darytų į alkūnės linkį arba nosinaitę, kurią nedelsiant išmestų.
Kontaktas su sergančiuoju
„Eurovaistinės“ farmacijos specialistė įspėja, kad tuo atveju, jeigu turėjote kontaktą su koronavirusu užsikrėtusiu žmogumi, taip pat reikalinga saviizoliacija. „Kaip ir sergančiam žmogui, rekomenduojama izoliuotis atskirame kambaryje ir turėti kuo mažiau kontaktų su kitais šeimos nariais, taip ir tam, kuris galimai turėjo kontaktą su užsikrėtusiu žmogumi“, – sako E. Ramaškienė.
Jeigu turėjote kontaktą su koronavirusu sergančiu žmogumi, labai svarbu stebėti, ar neatsiranda šiai ligai būdingi simptomai – karščiavimas, dažnas kosulys, dusinimas, skonio ir kvapo nejautimas. Pablogėjus savijautai svarbu kreiptis telefonu 1808 ir vadovautis visomis specialistų rekomendacijomis.
„Eurovaistinės“ farmacininkai rekomenduoja vengti nebūtino kontakto su kitais žmonėmis, daugiau laiko leisti namuose, dažnai plauti rankas, laikytis saugaus atstumo nuo aplinkinių.
Pranešimą paskelbė: Laura Bielskė, Eurovaistinė, UAB